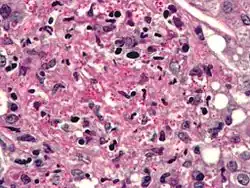

Pathogenic fungus
Pathogenic fungi are fungi that cause disease in humans or other organisms. Although fungi are eukaryotic, many pathogenic fungi are microorganisms.[1] Approximately 300 fungi are known to be pathogenic to humans;[2] their study is called "medical mycology". Fungal infections are estimated to kill more people than either tuberculosis or malaria—about two million people per year.[3]
In 2022 the World Health Organization (WHO) published a list of fungal pathogens which should be a priority for public health action.[4]
Markedly more fungi are known to be pathogenic to plant life than those of the animal kingdom.[5] The study of fungi and other organisms pathogenic to plants is called plant pathology.
Pathogens of particular concern
According to the World Health Organization (WHO) in 2022 pathogens of particular concern are:[4]
- Critical priority
- Cryptococcus neoformans, Candida auris, Aspergillus fumigatus, Candida albicans.
- High priority
- Nakaseomyces glabrata (Candida glabrata), Histoplasma spp., eumycetoma causative agents, Mucorales, Fusarium spp., Candida tropicalis, Candida parapsilosis.
- Medium priority
- Scedosporium spp., Lomentospora prolificans, Coccidioides spp., Pichia kudriavzeveii (Candida krusei), Cryptococcus gattii, Talaromyces marneffei, Pneumocystis jirovecii, Paracoccidioides spp.
Candida

Candida species cause infections in individuals with deficient immune systems. Candida species tend to be the culprit of most fungal infections and can cause both systemic and superficial infection.[6] Th1-type cell-mediated immunity (CMI) is required for clearance of a fungal infection. Candida albicans is a kind of diploid yeast that commonly occurs among the human gut microflora. C. albicans is an opportunistic pathogen in humans. Abnormal over-growth of this fungus can occur, particularly in immunocompromised individuals.[7] C. albicans has a parasexual cycle that appears to be stimulated by environmental stress.[8]
C. auris, first described in 2009, is resistant to many frontline antifungal drugs, disinfectants, and heat, which makes it extremely difficult to eradicate. Like many fungal pathogens it mostly affects immunocompromised people; if in the blood or other organs and tissues, mortality is about 50%.[3]
Other species of Candida may be pathogenic as well, including Candida stellatoidea, C. tropicalis, C. pseudotropicalis, C. krusei, C. parapsilosis, and C. guilliermondii.[9]
Aspergillus

The most common pathogenic species are Aspergillus fumigatus and Aspergillus flavus. Aspergillus flavus produces aflatoxin which is both a toxin and a carcinogen and which can potentially contaminate foods such as nuts. Aspergillus fumigatus and Aspergillus clavatus can cause allergic disease. Some Aspergillus species cause disease on grain crops, especially maize, and synthesize mycotoxins including aflatoxin. Aspergillosis is the group of diseases caused by Aspergillus. The symptoms include fever, cough, chest pain or breathlessness. Usually, only patients with weakened immune systems or with other lung conditions are susceptible.[1]
The spores of Aspergillus fumigatus are ubiquitous in the atmosphere. A. fumigatus is an opportunistic pathogen. It can cause potentially lethal invasive infection in immunocompromised individuals.[10] A. fumigatus has a fully functional sexual cycle that produces cleistothecia and ascospores.
Cryptococcus

Cryptococcus neoformans can cause a severe form of meningitis and meningo-encephalitis in patients with HIV infection and AIDS. The majority of Cryptococcus species live in the soil and do not cause disease in humans. Cryptococcus neoformans is the major human and animal pathogen. Papiliotrema laurentii and Naganishia albida, both formerly referred to Cryptococcus, have been known to occasionally cause moderate-to-severe disease in human patients with compromised immunity. Cryptococcus gattii is endemic to tropical parts of the continent of Africa and Australia and can cause disease in non-immunocompromised people.[1]
Infecting C. neoformans cells are usually phagocytosed by alveolar macrophages in the lung.[11] The invading C. neoformans cells may be killed by the release of oxidative and nitrosative molecules by these macrophages.[12] However some C. neoformans cells may survive within the macrophages.[11] The ability of the pathogen to survive within the macrophages probably determines latency of the disease, dissemination and resistance to antifungal agents. In order to survive in the hostile intracellular environment of the macrophage, one of the responses of C. neoformans is to upregulate genes employed in responses to oxidative stress.[11]
The haploid nuclei of C. neoformans can undergo nuclear fusion (karyogamy) to become diploid. These diploid nuclei may then undergo meiosis, including recombination, resulting in the formation of haploid basidiospores that are able to disperse.[13] Meiosis may facilitate repair of C. neoformans DNA in response to macrophage challenge.[13][14]
Histoplasma
Histoplasma capsulatum can cause histoplasmosis in humans, dogs and cats. The fungus is most prevalent in the Americas, India and southeastern Asia. It is endemic in certain areas of the United States. Infection is usually due to inhaling contaminated air.
Pneumocystis
Pneumocystis jirovecii (or Pneumocystis carinii) can cause a form of pneumonia in people with weakened immune systems, such as premature children, patients on immunosuppressive treatment, the elderly and AIDS patients.[15]
Stachybotrys
Stachybotrys chartarum or "black mold" can cause respiratory damage and severe headaches. It frequently occurs in houses and in regions that are chronically damp.[16]
Host defense mechanisms
Endothermy
Mammalian endothermy and homeothermy are potent nonspecific defenses against most fungi.[17] A comparative genomic study found that in opportunistic fungi there are few if any specialised virulence traits consistently linked to opportunistic pathogenicity of fungi in humans apart from the ability to grow at 37 °C.[18]
Barrier tissues
The skin, respiratory tract, gastrointestinal tract, and the genital-urinary tract induced inflammation are common bodily regions of fungal infection.
Immune response
Studies have shown that hosts with higher levels of immune response cells such as monocytes/macrophages, dendritic cells, and invariant natural killer (iNK) T-cells exhibited greater control of fungal growth and protection against systemic infection. Pattern recognition receptors (PRRs) play an important role in inducing an immune response by recognizing specific fungal pathogens and initiating an immune response. In the case of mucosal candidiasis, the cells that produce cytokine IL-17 are extremely important in maintaining innate immunity.[19]
Link to extremotolerance
A comprehensive comparison of distribution of opportunistic pathogens and stress-tolerant fungi in the fungal tree of life showed that polyextremotolerance and opportunistic pathogenicity consistently appear in the same fungal orders and that the co-occurrence of opportunism and extremotolerance (e.g. osmotolerance and psychrotolerance) is statistically significant. This suggests that some adaptations to stressful environments may also promote fungal survival during the infection.[18]
See also
- List of human diseases associated with infectious pathogens
- Microbiology
- Microsporidia
- Mycology
- Plant pathology
- Plague Inc.
References
- ^ a b c San-Blas G; Calderone RA, eds. (2008). Pathogenic Fungi: Insights in Molecular Biology. Caister Academic Press. ISBN 978-1-904455-32-5.
- ^ "Stop neglecting fungi". Nature Microbiology. 2 (8): 17120. 25 July 2017. doi:10.1038/nmicrobiol.2017.120. PMID 28741610.
- ^ a b Geddes, Linda (10 February 2023). "'A growing threat to human health': we are ill-equipped for the dangers of fungal infections". The Guardian.
- ^ a b WHO fungal priority pathogens list to guide research, development and public health action. World Health Organization. 2022. ISBN 978-92-4-006025-8.
- ^ English, Mary P. (1980). Medical Mycology. London: Edward Arnold Publishers Limited. p. 5. ISBN 0-7131-2795-3.
- ^ Turner, S. A.; Butler, G. (2014-09-01). "The Candida Pathogenic Species Complex". Cold Spring Harbor Perspectives in Medicine. 4 (9): a019778. doi:10.1101/cshperspect.a019778. ISSN 2157-1422. PMC 4143104. PMID 25183855.
- ^ Martins N, Ferreira IC, Barros L, Silva S, Henriques M (2014). "Candidiasis: predisposing factors, prevention, diagnosis and alternative treatment". Mycopathologia. 177 (5–6): 223–40. doi:10.1007/s11046-014-9749-1. hdl:1822/31482. PMID 24789109. S2CID 795450.
- ^ Bennett RJ (2015). "The parasexual lifestyle of Candida albicans". Curr. Opin. Microbiol. 28: 10–7. doi:10.1016/j.mib.2015.06.017. PMC 4688137. PMID 26210747.
- ^ Beneke, E. S. (1966). Medical Mycology: Laboratory Manual (2nd ed.). Minneapolis, MN: Burgess Publishing Company. p. 161.
- ^ O'Gorman CM, Fuller H, Dyer PS (2009). "Discovery of a sexual cycle in the opportunistic fungal pathogen Aspergillus fumigatus". Nature. 457 (7228): 471–4. Bibcode:2009Natur.457..471O. doi:10.1038/nature07528. PMID 19043401. S2CID 4371721.
- ^ a b c Fan W, Kraus PR, Boily MJ, Heitman J (2005). "Cryptococcus neoformans gene expression during murine macrophage infection". Eukaryotic Cell. 4 (8): 1420–33. doi:10.1128/EC.4.8.1420-1433.2005. PMC 1214536. PMID 16087747.
- ^ Alspaugh JA, Granger DL (1991). "Inhibition of Cryptococcus neoformans replication by nitrogen oxides supports the role of these molecules as effectors of macrophage-mediated cytostasis". Infect. Immun. 59 (7): 2291–6. doi:10.1128/IAI.59.7.2291-2296.1991. PMC 258009. PMID 2050398.
- ^ a b Lin X, Hull CM, Heitman J (2005). "Sexual reproduction between partners of the same mating type in Cryptococcus neoformans". Nature. 434 (7036): 1017–21. Bibcode:2005Natur.434.1017L. doi:10.1038/nature03448. PMID 15846346. S2CID 52857557.
- ^ Bernstein H, Bernstein C, Michod RE (2018). "Sex in microbial pathogens". Infection, Genetics and Evolution. 57: 8–25. Bibcode:2018InfGE..57....8B. doi:10.1016/j.meegid.2017.10.024. PMID 29111273.
- ^ Ryan KJ; Ray CG, eds. (2004). Sherris Medical Microbiology (4th ed.). McGraw Hill. ISBN 978-0-8385-8529-0.
- ^ Bitnun, Ari; Nosal, Robert M (1999). "Stachybotrys chartarum (atra) contamination of the indoor environment: Health implications". Paediatrics & Child Health. 4 (2): 125–129. doi:10.1093/pch/4.2.125. ISSN 1205-7088. PMC 2828207. PMID 20212975.
- ^ Robert, V. A.; Casadevall, A. (2009). "Vertebrate Endothermy Restricts Most Fungi as Potential Pathogens". The Journal of Infectious Diseases. 200 (10): 1623–1626. doi:10.1086/644642. PMID 19827944.
- ^ a b Gostinčar, Cene; Zajc, Janja; Lenassi, Metka; Plemenitaš, Ana; de Hoog, Sybren; Al-Hatmi, Abdullah M. S.; Gunde-Cimerman, Nina (2018-11-01). "Fungi between extremotolerance and opportunistic pathogenicity on humans". Fungal Diversity. 93 (1): 195–213. doi:10.1007/s13225-018-0414-8. hdl:20.500.12556/DiRROS-19656. ISSN 1878-9129.
- ^ Brown GD, Drummond RA, Gaffen SL, Hise AG (2015). "Innate Defense against Fungal Pathogens". Cold Spring Harb Perspect Med. 5 (6): a019620. doi:10.1101/cshperspect.a019620. PMC 4426252. PMID 25384766.
Further reading
- Almeida F, Rodrigues ML, Coelho C (2019). "The Still Underestimated Problem of Fungal Diseases Worldwide". Front Microbiol. 10: 214. doi:10.3389/fmicb.2019.00214. PMC 6379264. PMID 30809213.